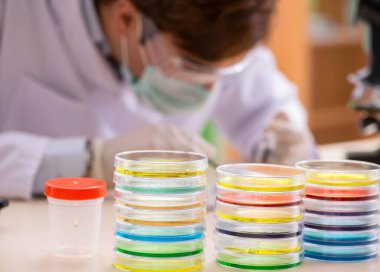
Laboratuvarda çalışan genç bir kimyager.

Paslanmaz çelik bir yüzeye yerleştirilmiş birden fazla petri kabının yüksek çözünürlüklü yakın çekimi, her tabağın içinde deneysel veya sanatsal reaksiyonlar sonucu canlı renk patlamaları içeriyor..
Özel Boyut
(5376 x 3072, jpg)
Geniş Lisanslama
(5376 x 3072, jpg)
En Çok Aranan Kelimeler
RenkRenkliCanlıYakın planmakroCamparlaksanatSıvıSoyutdokuGeçerliÇelikDesenTıbbitabakmodernpatlamaKavramGeleceğe yönelikTemizDinamikkültüreğilimörnekyüzeybiyolojiKimyasalDeneyLaboratuvarBilimpaslanmazPaletSimetriHücreleraraştırmaBilimselortamdaireselsterilTepkiTabaklarMikrobiyolojiNeonPetriyüksek çözünürlüklüPetri kabıBioartpetriartBenzer İçerikler